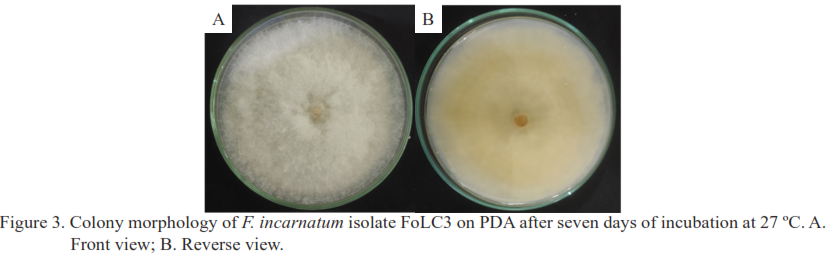

Articles
Augmentorium devices: A sanitation tools for control fruit flies and augmentation parasitoids of fruit flies on chilli plants
280-289 Pages
Effectiveness of entomopathogenic fungal combinations on eggs and larval development of Spodoptera frugiperda J.E. Smith (Lepidoptera: Noctuidae) in corn plants
290-303 Pages
Termite symbiont bacteria as biological agents against anthrachnose of bird’s eye chilli caused by Colletotrichum sp.
304-316 Pages
First report of Fusarium incarnatum causing fruit rot of chili pepper in Indonesia
317-326 Pages
Enhanced nematicidal potential of MnCl2-fortified Bacillus sp. cell-free supernatant against Meloidogyne incognita
327-341 Pages
Chitosan derived from crab shell waste: A natural coating against anthracnose disease in Capsicum annuum L. (Chilli)
342-352 Pages
Characterization antagonism of Nigrospora spp. against Fusarium solani causing Fusarium wilt in Capsicum frutescens L. plants
353-362 Pages
Overview of infestation status and management of the rice leaffolder, Cnaphalocrocis medinalis (Guenée) (Lepidoptera: Pyralidae), in Malaysian paddy areas
363-378 Pages
Molecular detection and characterization of potato virus Y-NTN and cucumber mosaic virus-S in microtubers and G0 tubers of red and Granola potato
379-389 Pages